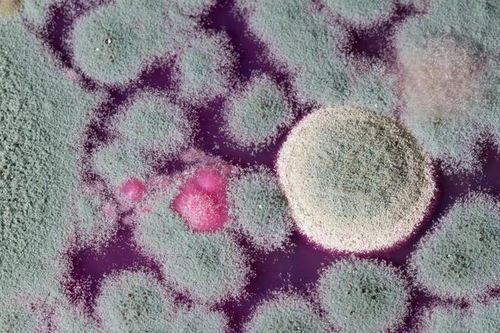
ô

春天脸部过敏怎么办
皮肤病 2025-11-27 15:20皮肤病种类www.pifubingw.cn
如何应对春季脸部过敏的困扰?
春天来临,万物复苏,脸部过敏问题也随之而来。面对春天的粉尘、花粉、尘螨等过敏源,许多人会感到脸部不适。那么,如何应对春季脸部过敏呢?
对于容易过敏的人群来说,寻找过敏源是首要任务。建议到医院进行检查,确定过敏源后尽量避免接触。如果无法避免,可以考虑进行脱敏治疗,逐渐让身体适应这些过敏源。
在过敏发生时,除了避免过敏源,药物治疗也是必要的。可以口服抗过敏药物,如依巴斯丁、氯雷他定、酮替酚等,这些药物能有效抗炎、抗过敏。局部也可以使用抗过敏、抗炎的药膏,如地奈德乳膏、氢化可的松乳膏等。
除了药物治疗,日常护理也非常重要。春天脸部过敏的患者应注意以下几点:
1. 保持皮肤清洁:早晚用温水洗脸,避免使用刺激性的洁面产品。
2. 防晒:避免阳光直接照射脸部,外出时请涂抹防晒霜或使用遮阳帽。
3. 饮食调理:避免食用容易引起过敏的食物,如海鲜等。多吃新鲜蔬果,增强免疫力。
4. 注意情绪调节:保持良好的心态,避免情绪波动诱发过敏。
应对春季脸部过敏,关键在于找出过敏源,避免或去除,同时进行脱敏治疗和药物治疗。注意日常护理和饮食调理,提高身体免疫力,远离过敏困扰。让我们在春天享受美丽的季节,远离过敏的烦恼。
上一篇:孕期湿疹为什么老反复
下一篇:没有了